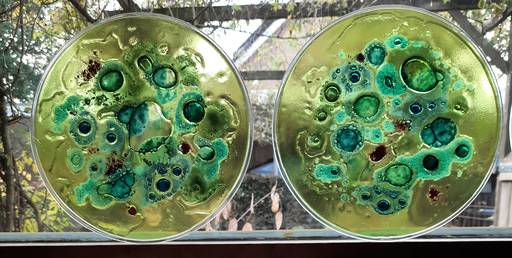

Welkom op de website van Ineke Oomen- de Voogelaar
Sinds enkele jaren werk ik met glas in lood en tiffany en ik heb daarvoor een cursus gevolgd bij Lisette Martens in Hollandscheveld.
Ik vind de kleuren en het effect van het licht dat door het glas valt prachtig. Mijn raamhangers maak ik naar eigen ontwerp. Niet te ingewikkeld, maar zo eenvoudig mogelijk , hoe meer glas hoe liever.
Bij mijn opleiding tot onderwijzeres heb ik bij mijn keuzevak kunstgeschiedenis een scriptie gemaakt over glas in lood en gebrandschilderde ramen. Ik woonde toen in Biervliet ( mijn geboorteplaats ) en in de Hervormde Kerk waren prachtige gebrandschilderde ramen. Een paar jaar geleden ben ik er weer geweest en heb toen een rondleiding door het dorp gemaakt met o.a.een bezoek aan de Ned. Hervormde Kerk en Katholieke Kerk. Ik raad iedereen aan, die daar in de buurt is, dit ook te doen.
Torenakker 45
7963CB Ruinen
email : inekeoomen@hotmail.com
tel: 0624181054